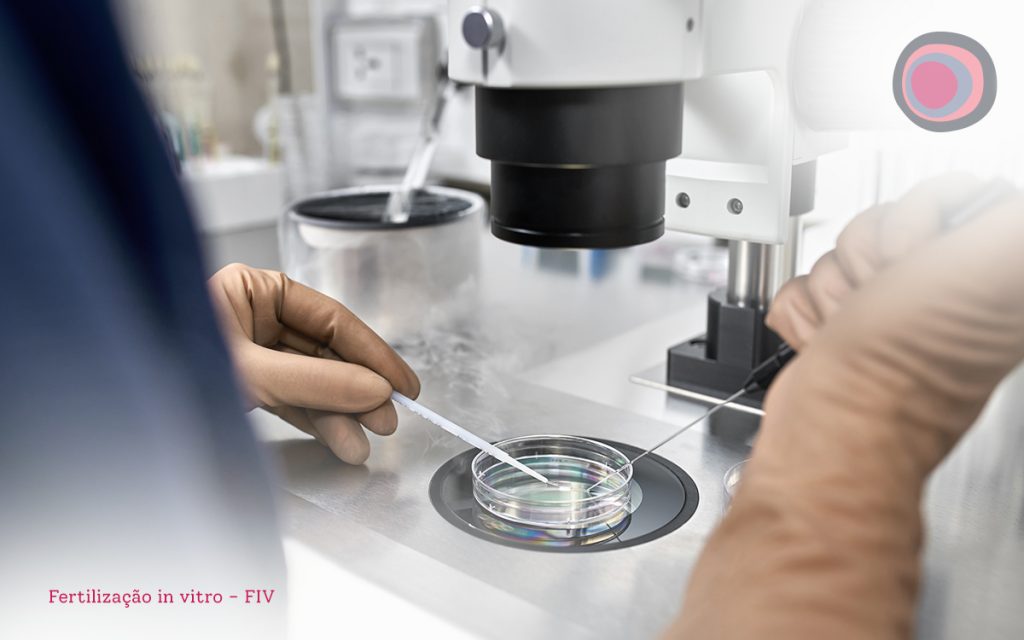

497
A endometriose é uma das doenças ginecológicas mais recorrentes em mulheres em idade fértil, prevalente em até 10% da população mundial e responsável por até 50% dos casos de infertilidade feminina.
Caracterizada pelo crescimento de endométrio ectópico – fora da cavidade uterina – em diversos órgãos e estruturas da cavidade pélvica, inclusive nos ovários, a endometriose causa sintomas às vezes bastante incômodos, até incapacitantes, que incluem dor pélvica, dismenorreia e dispareunia de profundidade, além de infertilidade.
O crescimento desse tecido endometrial ectópico é estimulado pela ação do estrogênio, que por sua vez é um hormônio natural do ciclo reprodutivo e atinge picos de concentração a cada ciclo.
Isso faz da endometriose também uma doença crônica e progressiva, que pode evoluir para quadros mais graves, bastante dolorosos, se não tratada de forma correta e precoce.
A classificação da endometriose é feita de acordo com o local de aparecimento dos focos da doença, com a profundidade que essas infiltrações alcançam e com a quantidade de lesões, que podem inclusive acometer mais de um órgão ou estrutura simultaneamente.
Os locais em que os focos mais surgem são: ovários, peritônio, ligamentos uterossacros, tubas uterinas, septo retovaginal, reto e bexiga.
Quando afeta os ovários, a endometriose ovariana é chamada de endometriomas, que são cistos avermelhados, cuja presença prejudica a reserva ovariana e a ovulação de forma geral.
Os endometriomas são a forma de endometriose que mais afeta a fertilidade das mulheres e a demora em buscar tratamento médico é um dos principais fatores de risco para que a doença cause infertilidade.
Este texto aborda a relação entre os endometriomas e a infertilidade. Aproveite a leitura!
Endometriomas são cistos avermelhados, conhecidos como cistos de chocolate, formados por tecido endometrial ectópico nos casos de endometriose do tipo ovariana e crescem no córtex dos ovários pela estimulação hormonal dos estrogênios.
O crescimento desses cistos aumenta a pressão interna dos ovários e pode danificar os folículos ovarianos ali presentes, afetando a reserva ovariana. Além disso, a interferência dos cistos também pode simplesmente interromper a ovulação, causando infertilidade por anovulação.
A origem da endometriose e, consequentemente, dos endometriomas ainda é discutida pela medicina, porém a hipótese mais aceita é a teoria de Sampson ou teoria da menstruação retrógrada.
Segundo essa teoria, algumas mulheres podem um fluxo de sangue durante a menstruação em que parte é eliminado e parte do sangue retorna para órgãos e estruturas pélvicas, uma espécie de refluxo.
No entanto, sabe-se que muitas mulheres têm menstruação retrógrada, mas não desenvolvem endometriose. Hoje sabemos que há aspectos imunológicos relacionados ao desenvolvimento da doença. O corpo nem sempre consegue combater esses focos ectópicos e a doença se desenvolve.
A reserva ovariana é um termo técnico usado para designar a quantidade de folículos nos ovários de uma mulher, em um determinado momento. A formação da reserva ovariana acontece toda durante o período embrionário, e a mulher já nasce com a quantidade total de folículos disponíveis por toda sua vida, estacionados em uma fase das divisões celulares que originam os óvulos.
Na puberdade, esses processos são retomados após alterações no padrão de secreção dos hormônios do eixo hipotálamo-hipófise-gonadal, especialmente o GnRH (hormônio liberador de gonadotrofinas), as gonadotrofinas, os estrogênios e a progesterona, e a mulher passa a liberar um óvulo por ciclo reprodutivo, que pode ou não ser fecundado.
Dessa forma, ao longo da vida fértil, a mulher vai consumindo naturalmente a reserva ovariana a cada ciclo reprodutivo, até que a partir dos 35-37 anos, esse estoque demonstra um declínio mais intenso, que culmina com seu fim na menopausa.
Algumas doenças, como a endometriose, mais especificamente os endometriomas, podem acelerar a diminuição da reserva ovariana e, assim, intensificar o declínio da fertilidade nas mulheres.
Isso acontece porque os cistos típicos da endometriose ovariana exercem pressão no interior dos ovários, danificando as células reprodutivas e interferindo em seu processo de amadurecimento.
A mulher pode apresentar infertilidade por anovulação, já que os folículos não conseguem amadurecer em virtude dos cistos, e também uma perda mais intensa de fertilidade a médio e longo prazo decorrente dos danos físicos à reserva ovariana.
O tratamento para endometriomas pode ser feito com anticoncepcionais orais combinados ou retirada cirúrgica dos cistos. Isso depende de alguns fatores, principalmente sintomas e desejo de engravidar.
Quando a cirurgia é indicada, o primeiro passo recomendado é a preservação da fertilidade. A paciente passa pela estimulação ovariana e os óvulos são retirados e congelados. Dessa forma, ela pode engravidar no futuro quando tiver esse desejo.
Depois disso o procedimento pode ser feito. A retirada dos endometriomas é feita por videolaparoscopia e costuma ser bem-sucedida no tratamento dos sintomas, porém a fertilidade geralmente é prejudicada, principalmente em casos mais severos da doença.
Nesses casos, a paciente pode recorrer às técnicas de reprodução assistida. A mais indicada é a FIV (fertilização in vitro), de alta complexidade. É só na FIV que os óvulos congelados podem ser utilizados.
Para saber mais sobre a endometriose, toque aqui.
Compartilhe:
Último Post: